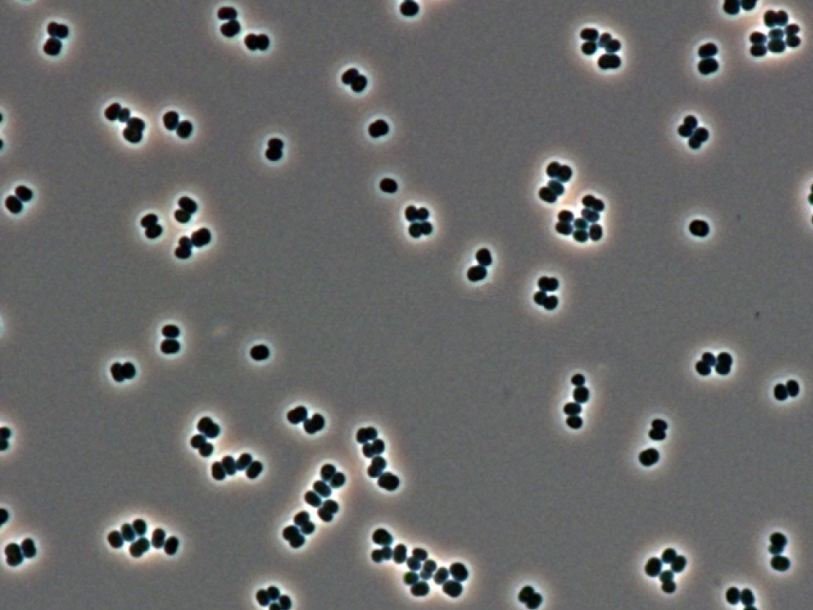

Бактерии в стерильных комнатах NASA ставят под вопрос поиск внеземной жизни
Интеллектуальный партнер проекта Исследователи Американского космического агентства (NASA) нашли новый вид бактерий в двух стерильных комнатах, которые используются для строительства космических кораблей. Информация об этом появилась на сайте ведомства.
Как считалось ранее, условия, поддерживаемые в стерильных помещениях, убивают любые живые микроорганизмы. Этому способствует отсутствие влаги, чистка при помощи химических веществ, отрицательное давление воздуха, которое предотвращает попадание загрязнителей снаружи, термообработка и ультрафиолет. Все сотрудники, работающие в стерильных помещениях, надевают стерильную спецодежду.
Бактерии, названные Tersicoccus phoenicis (tersi по-латыни «чистый», coccus в переводе с греческого «ягода» (по форме бактерия похожа на ягоду), phoenicis — в честь космического аппарата Феникс, во время строительства которого бактерии впервые были обнаружены), ученые нашли в двух чистых комнатах, расположенных во Флориде и на космодроме Куру во Французской Гвиане.
При изучении микроорганизма его отнесли к новому, ранее неизвестному виду. По словам микробиолога NASA Парага Вайшампайана (Parag Vaishampayan), поразительная живучесть этих бактерий делает возможным их выживание на космическом корабле, что ставит под сомнение поиск внеземной жизни.